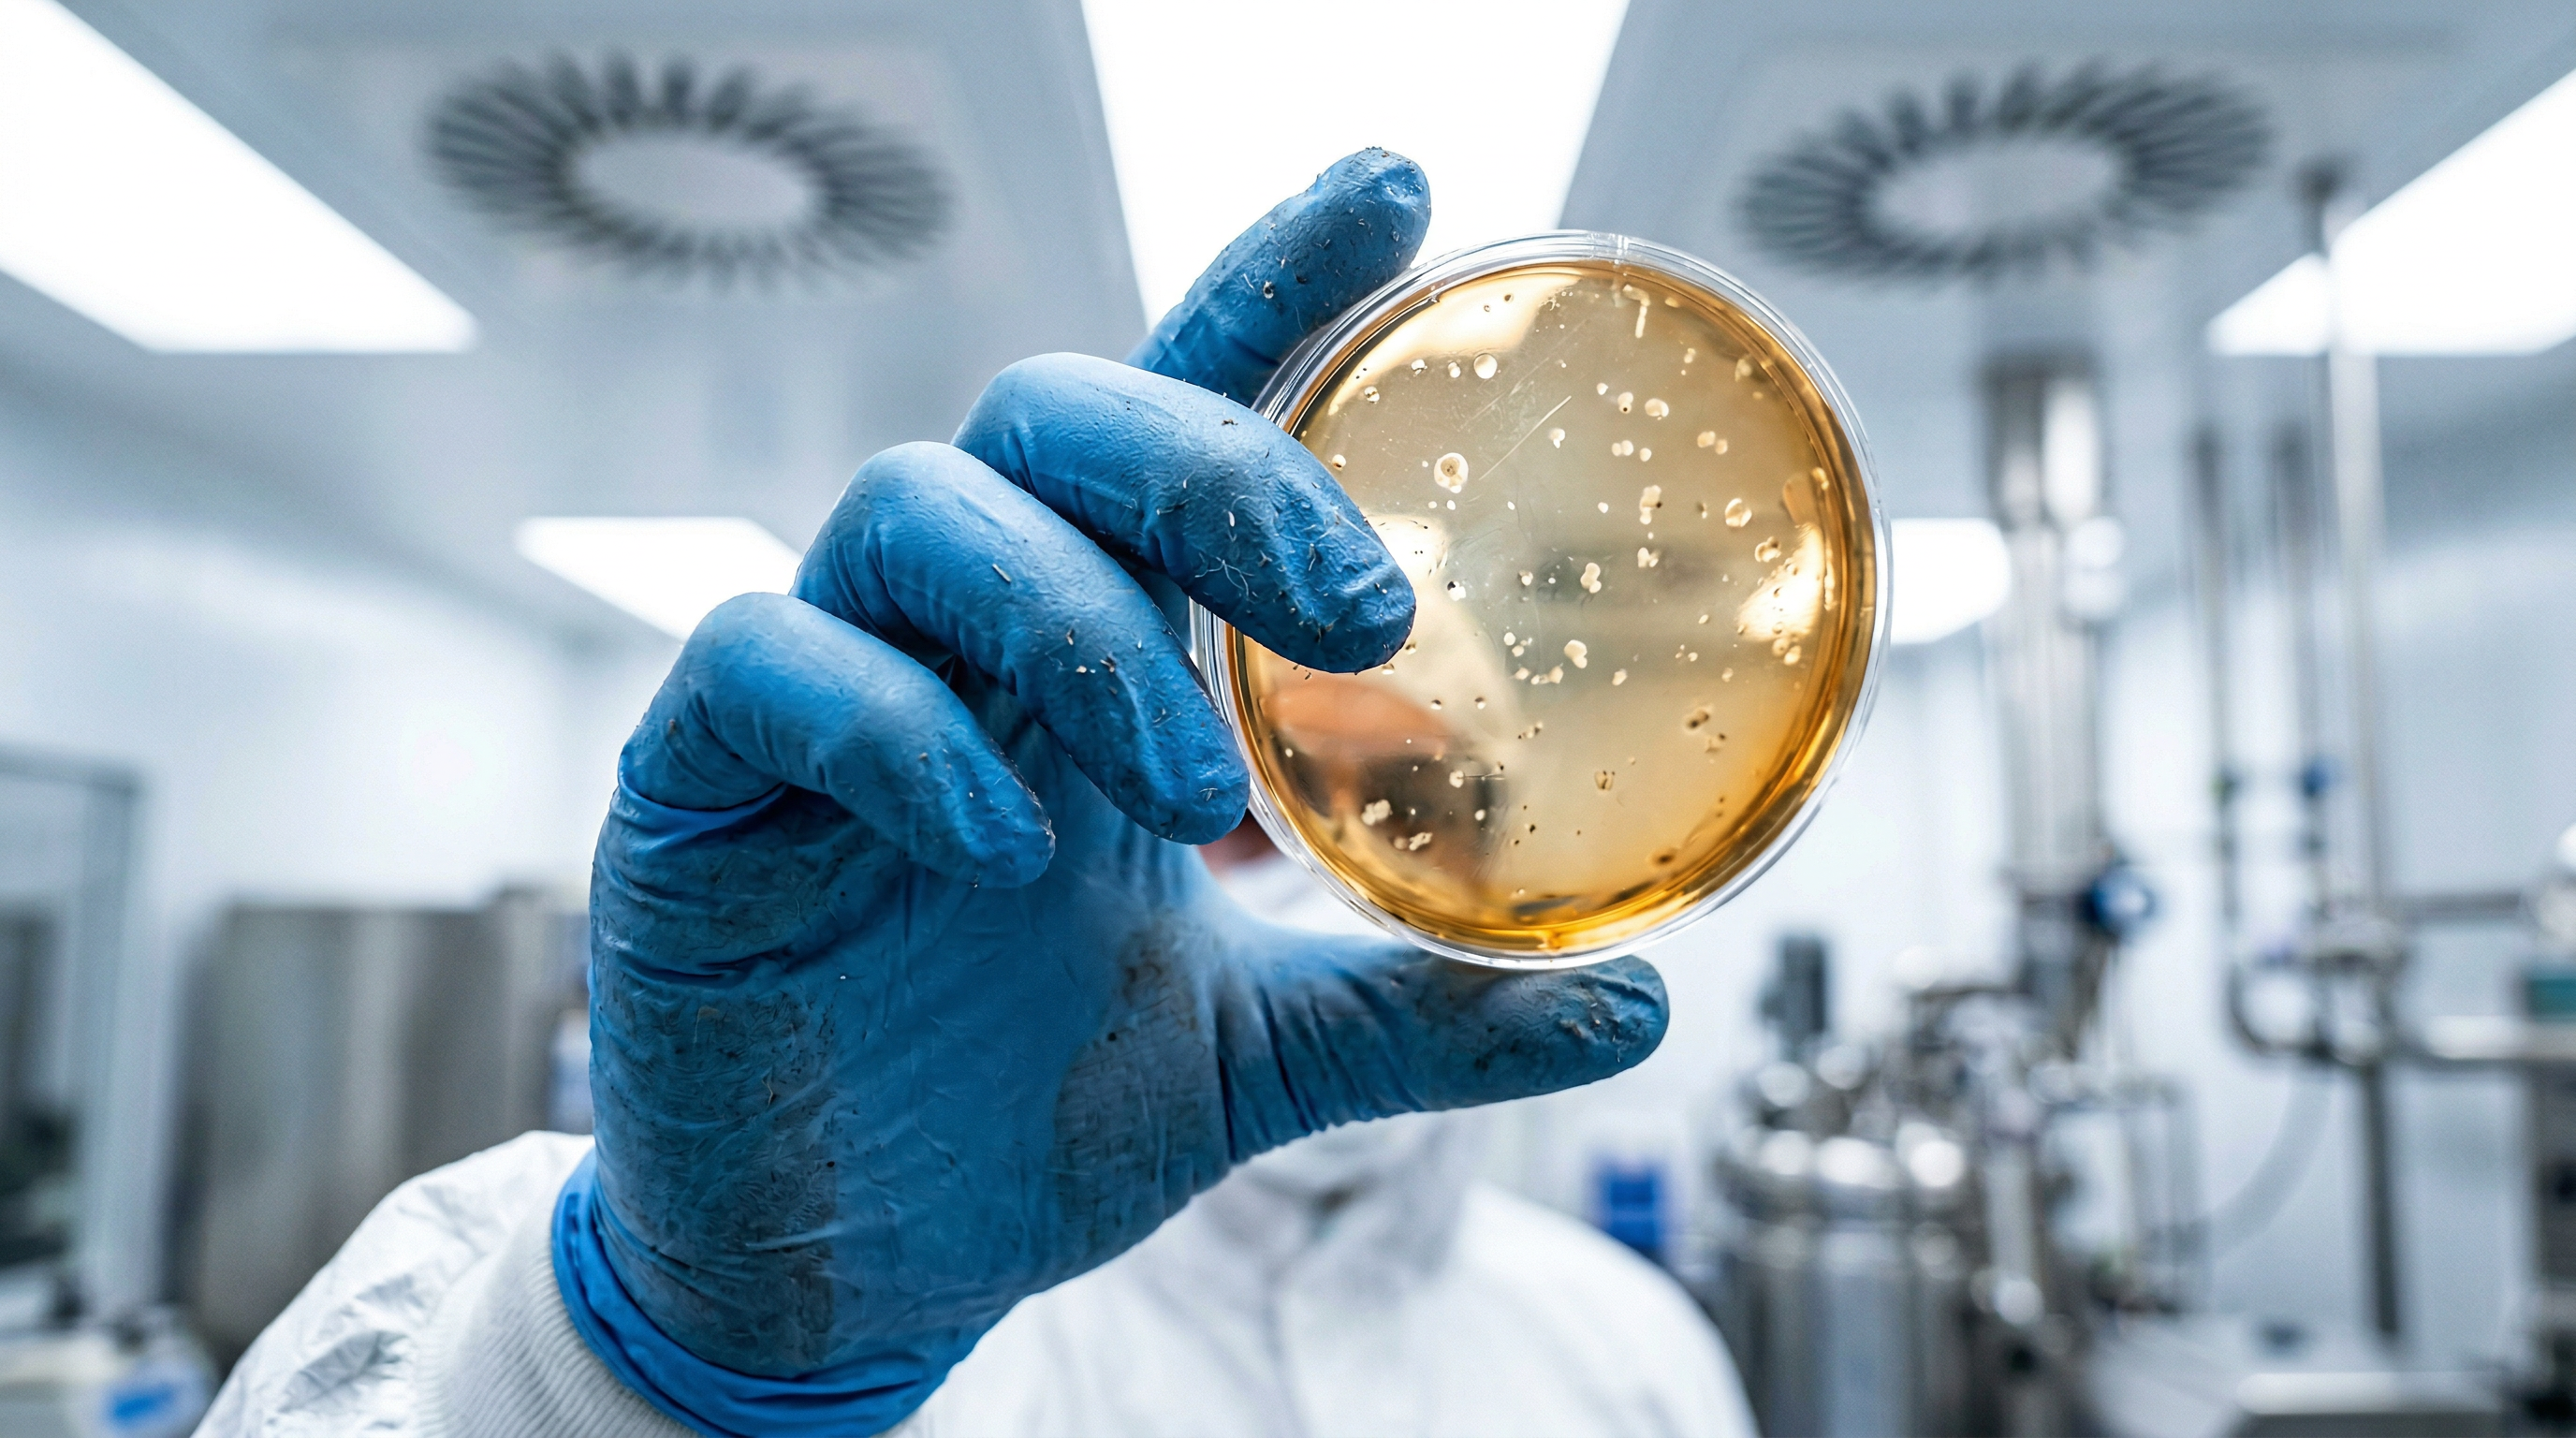
ISO 14644 cleanroom interior — modular cleanroom construction in Baja California

— About Us Tech Ingenieros
36+ YEARS BUILDING MISSION-CRITICAL INFRASTRUCTURE.
Founded in 1990, Us Tech Ingenieros is a design-build engineering firm headquartered in Tijuana, Baja California, with active operational capacity across Northwest Mexico and the U.S. border corridor — specializing in cleanroom construction, industrial electrical installations, and controlled environments for high-reliability maquiladora operations.
With full operational capacity across the region, we deliver immediate on-site response and reduced logistics costs for maquiladora clients. We serve the entire Baja California industrial corridor with integrated solutions where compliance, uptime, and performance are non-negotiable.
We serve industries with the highest technical and regulatory demands: aerospace, medical devices, pharmaceuticals, advanced manufacturing, and data centers, executing under strict standards including ISO 14644, FDA 21 CFR, AS9100, NEC 2023, NFPA 70E, and NOM-001-SEDE 2012.
Our approach integrates engineering, construction, and execution into a single accountable structure, eliminating fragmentation, reducing risk, and ensuring systems perform as designed from day one.
Track Record
1990
Founded in Riverside, California. Initial industrial electrical projects supporting the maquiladora sector.
2000
Expansion into cleanroom design and construction for pharmaceutical and medical device industries.
2010
Execution of aerospace projects aligned with AS9100 requirements for U.S. defense suppliers.
2018
Launch of Applied Engineering division: power system studies (ETAP / SKM), arc flash analysis, and power quality.
2026
Headquartered in Tijuana, Baja California, with full operational capacity across Northwest Mexico. 36+ years of experience and 254+ completed projects serving maquiladoras and industrial facilities throughout the border region.
 Medical Devices
Medical Devices
 General Contractor
General Contractor
 Medical Devices
Medical Devices
 Electrical Contractor
Electrical Contractor
 Medical Devices
Medical Devices
 Medical
Medical
 Medical Devices
Medical Devices
 Medical Devices
Medical Devices
 Cleanroom Contractor
Cleanroom Contractor
 Medical Devices
Medical Devices
 General Contractor
General Contractor
 Medical Devices
Medical Devices
 Electrical Contractor
Electrical Contractor
 Medical Devices
Medical Devices
 Medical
Medical
 Medical Devices
Medical Devices
 Medical Devices
Medical Devices
 Cleanroom Contractor
Cleanroom Contractor